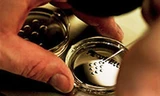
Tiêm tế bào gốc: Tốn tiền triệu, coi chừng ung thư!

Ngày 24/8, Khoa Thẩm mỹ da Bệnh viện (BV) Da Liễu TPHCM cho biết, đơn vị này gần đây tiếp nhận nhiều trường hợp bệnh nhân đến khám và điều trị trong tình trạng mặt sưng phù, nổi nhiều nốt sần đỏ…do tiêm tế bào gốc.
Mới đây, chị N.T.H (45 tuổi, ngụ Q.2) đến khám tại khoa Thẩm mỹ da trong tình trạng mặt sưng phù, nhiều nốt bầm tím… Chị H cho biết trước đó có đến thẩm mỹ viện tại quận 2 và được nhân viên ở đây tư vấn tiêm tế bào gốc của Hàn Quốc để làm trẻ hóa da. Sau tiêm một ngày, mặt người phụ nữ này sưng phù, đau nhức.
Trước đó khoảng một tuần, khoa Thẩm mỹ da cũng tiếp nhận một bệnh nhân nữ 40 tuổi mặt nổi đầy nốt sần đỏ... Bệnh nhân cho biết trước đó mấy ngày có tiêm tế bào gốc tại một spa. Sau tiêm mặt nổi đầy các nốt sẩn đỏ, mãi không tan, mất thẩm mỹ nên chị đến bệnh viện nhờ can thiệp.
 Nhiều phụ nữ chọn tiêm tế bào gốc để làm đẹp
Nhiều phụ nữ chọn tiêm tế bào gốc để làm đẹp Ths. BS Trần Nguyên Ánh Tú – Phó Trưởng khoa Thẩm mỹ da BV Da Liễu TPHCM cho biết, trong nhiều năm gần đây rộ lên phương pháp làm đẹp bằng tế bào gốc. Tuy nhiên, cho đến thời điểm hiện nay, tại Việt Nam, chưa có cơ sở y tế nào được Bộ Y tế cấp phép triển khai kỹ thuật ứng dụng công nghệ tế bào gốc trong lĩnh vực da liễu và thẩm mỹ.
“Sản phẩm mà các thẩm mỹ viện, spa tiêm cho 2 bệnh nhân trên thực chất chỉ được “dán nhãn tế bào gốc” mà không hề có bất cứ một tế bào gốc sống nào trong sản phẩm. Nguyên nhân gây ra tai biến là do các thành phần có trong sản phẩm tiêm vào da gây phản ứng trên cơ thể” - BS Ánh Tú cho biết.
Theo BS Ánh Tú, gần đây một số nước trên thế giới đã có nghiên cứu ứng dụng tế bào gốc trong điều trị các bệnh lý da miễn dịch và hệ thống như vảy nến, xơ cứng bì hệ thống, ly thượng bì bóng nước hay ung thư da… Riêng trong lĩnh vực thẩm mỹ, tế bào gốc cũng được nghiên cứu để điều trị tình trạng lão hóa da, sẹo xấu, sẹo bỏng...
Việc ứng dụng tế bào gốc trong da liễu nói chung và thẩm mỹ, chăm sóc da nói riêng vẫn đang được tiếp tục nghiên cứu để có nhiều chứng cứ khoa học rõ ràng về hiệu quả và tính an toàn của tế bào gốc trước khi áp dụng điều trị rộng rãi cho bệnh nhân.
Hiện trên thị trường có rất nhiều “sản phẩm tế bào gốc” với giá cả rất khác nhau, từ vài trăm ngàn đến cả trăm triệu đồng. Theo BS Ánh Tú, việc chiết tách tế bào gốc đòi hỏi kỹ thuật phức tạp, bao gồm quay ly tâm, ly giải hồng cầu và collagen, rửa, phân đoạn mô đệm mạch (stromal vascular fraction, SVF)…
Môi trường nuôi cấy của các tế bào gốc cũng đòi hỏi những tiêu chuẩn nghiêm ngặt như phải đảm bảo vô trùng, phải bảo quản ở nhiệt độ từ -80oC… Vì vậy, không thể có sản phẩm tế bào gốc giá vài trăm ngàn đồng.
 Bệnh viện Da liễu TPHCM mỗi tháng tiếp nhận từ 5-7 bệnh nhân bị tai biến so tiêm tế bào gốc trôi nổi (ảnh: BVCC)
Bệnh viện Da liễu TPHCM mỗi tháng tiếp nhận từ 5-7 bệnh nhân bị tai biến so tiêm tế bào gốc trôi nổi (ảnh: BVCC) Các chuyên gia y tế cho rằng, ngay cả những sản phẩm có chứa tế bào gốc thì việc tiêm vào cơ thể cũng tiềm ẩn nhiều rủi ro. Ví dụ, các trường hợp chiết tách tế bào gốc cùng loại mô nhưng có nguồn gốc từ những người khác nhau có thể gây ra phản ứng dị ứng, hay nặng hơn là tình trạng thải mảnh ghép khởi phát sau nhiều năm điều trị.
Đặc biệt, phản ứng dị ứng vẫn có thể xảy ra ngay trong trường hợp lấy tế bào gốc từ cơ thể của một người và sử dụng cho chính người đó do nguy cơ dị ứng đến từ các thành phần, hợp chất trong quá trình nuôi cấy.
Đó là chưa kể, khi tiêm tế bào gốc vào cơ thể, chúng ta không thể kiểm soát hoàn toàn được sự phát triển và biệt hóa của các tế bào gốc sẽ diễn ra trong cơ thể như thế nào, dẫn đến việc xuất hiện các khối u thứ phát. Do đó, công nghệ tế bào gốc không an toàn 100% như quảng cáo.
Trung bình mỗi tháng, khoa Thẩm mỹ da BV Da Liễu TPHCM tiếp nhận từ 5-7 bệnh nhân bị tác dụng phụ, tai biến khi sử dụng các “sản phẩm tế bào gốc” dưới dạng tiêm, bôi, uống. Việc điều trị những tai biến này mất nhiều thời gian và chi phí, và có nhiều trường hợp phục hồi không hoàn toàn để lại di chứng trên da. Vì vậy, trước khi quyết định sử dụng các sản phẩm, dịch vụ thẩm mỹ nói chung và sản phẩm tế bào gốc nói riêng, chị em cần tham khảo ý kiến chuyên gia ở các cơ sở y tế uy tín và được cấp phép để tránh “tiền mất, tật mang” - BS Ánh Tú khuyến cáo.